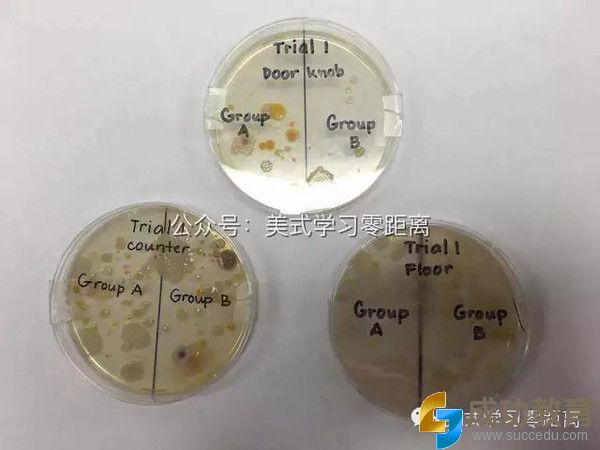
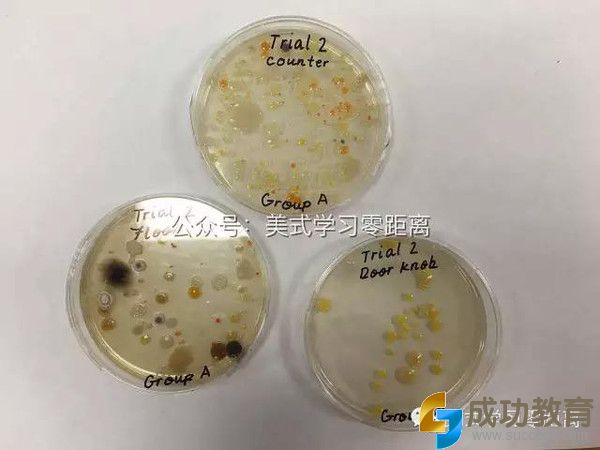
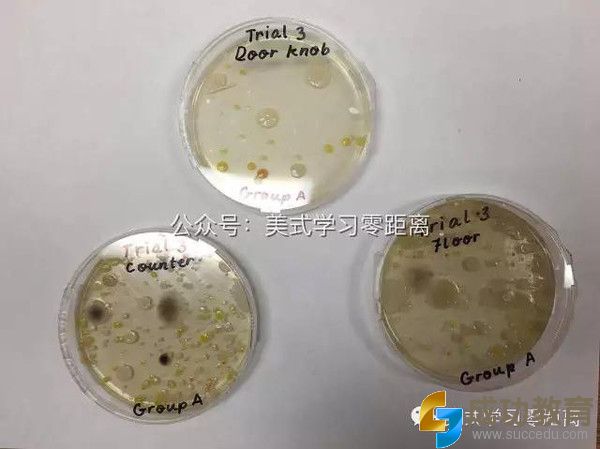

刷爆朋友圈的"引力波",美国小学是如何教给7岁孩子
100年前,有一个怪老头运用他非人类的脑袋瓜从广义相对论推理出了一种叫做“引力波”的东西, 这个怪老头的名字叫做“爱因斯坦”。但是这个叫做“引力波”的东西到底存不存在,我们这些正常人类一直没有弄明白。
100年以后的今天,我7岁的儿子回到家,很兴奋、很神秘的跟我说“妈妈,你知道引力波吗?老师今天说它被证明出来了哦!” “啥波?” “引力波Gravitational Waves,Mom, you didn't know that?”儿子接着说“引力波是爱因斯坦在100年前提出来的一个假说(Hypothesis), 然后科学家们用了100年做实验才证明了它的存在哦!老师说引力波具体是什么,我们现在还理解不了,不过她说科学家用来证明引力波所用的科学方法和我们上课讲的差不多,都是先提出一个假说(Hypothesis), 然后做实验,采集数据,最后得出结论。。。” 正在切菜的我,差点一刀下去切掉我半个指甲。我没想到这几天被朋友圈刷屏的大话题——“引力波”,居然连一个7岁的孩子都知道,而且还和我大谈科学方法。
晚上老公回家,儿子一直缠着老公问“引力波”。虽然我不知道一个7岁的孩子到底能够理解多少,但是我相信今天在学校里老师提到的“引力波”这个词,他是记住了。我很吃惊美国的学校,老师会跟这么小的孩子提到这么深奥的物理概念,但是至少老师对于每天世界上最新的科学探索事件,是关心的,也是乐于引导和传播给孩子们的,而且还能联系到课堂上的内容,真是不容易。
在中国,老师对于知识的讲授,更多的是对前人知识结论性的归纳和总结。而在美国,老师更强调方法的传授。
而何为科学方法论,让我们先看一下儿子最近的一场关于“细菌”的科学汇报吧。
首先老师提出了一个问题,教室里哪里细菌最多?
于是孩子们分别提出了他们的假说(Hypothesis)——有的说地板最脏,所以地板上的细菌最多;有的说教室里的试验台上细菌最多,更有个别孩子甚至说门把手上细菌最多。但是提出了假说之后,孩子们需要证明他们的假说。
接着孩子们在老师的帮助下做出了一个计划:把地板上的细菌数量和试验台上的细菌以及门把手上的细菌数量进行比较。
怎么比较呢?显然肉眼是看不到细菌的,但是老师并不提供显微镜给他们使用。老师告诉他们,有些东西直接无法测量的时候,可以用间接的办法,最后在老师的引导下,小孩子们得到了下面的实验计划:
先用三块干净的试纸分别擦地板、试验台和门把手,然后把试纸上擦到的东西移到培养皿里面密封起来。接着把培养皿放在一个台灯下面照射3天保持温度。3天以后便可以用肉眼直接观察细菌的数量了。
另外,为了防止实验的误差,老师叫小朋友们每个实验做三次,这样可以防止一些偶然因素对实验结果的影响。所以地板细菌,试验台细菌和门把手细菌的培养皿各有三个。
下面的图是孩子们最后的实验结果。

这张图是儿子自己绘制的实验结果图表。

听完汇报回来,儿子他爹一直在感慨中国和美国在科学教育方面的巨大差别。儿子他爹是大家眼中的学霸,在美国斯坦福大学拿到博士。他说在他受教育的过程中,就算在大学里,老师也没有把科学方法独立拿出来讲的,而儿子他们一年级就开始讲了。而且这一套方法,就算是在做博士毕业论文的时候,也是一脉相承的。
这就是美国课堂上老师教会孩子们的实验方法
1.阐述问题(你想发现些什么?)
2. 形成一个假说——可以是一个猜想(你设想会发生什么样的情况?)3.计划——(你需要那些材料来完成你的实验)
4.过程(一步一步的列出过程去测试之前的假设)
5.结果(最后发生了什么样的情况)
6.结论(从中学到什么?问题的答案是什么?你之前的假设正确吗?)

最后让我们看一下孩子们自己制作的科学实验展板吧。孩子们除了每个人会分别上台进行汇报之外,也需要分工合作制作展板。汇报结束后,儿子兴奋的告诉我,哪一部分是他做的,甚至哪几个细菌是他画的。看得出,孩子们从这次科学实验中学到了不少东西。




中美教育在很多方面存在差异性,美国有很多不错的教育理念值得借鉴。我相信现在中国应该已经也有不少学校开始借鉴这些东西了。从今天这个话题出发,我最大的体会是,美国教育很多时候是让孩子们带着问题主动的去寻求答案,而这个答案很多时候都不一定是标准答案。而中国的教育更适应于一个权威的统一标准答案。
并且美国老师会把深奥的引力波的证明和小朋友做的细菌的科学实验联系在一起,让他们觉得自己做的东西在某些地方和伟大的科学家是相似的,这会大大提高孩子们的兴趣。我想就这一点上来,老师真是费了一番苦心。
★★★★★★★★★★★★★★★★★
想了解最新的幼儿入园、幼升小、小升初、中考、高考等教育信息,请关注微信公众号:成都教育(微信号:chendujiaoyu)。
- 上一篇
上海名校长对未来教育的预测,你教娃可能错了!
看点 今天来到“校长堂”的是上海平和双语学校校长万玮。在视频访谈中,万校长辨析了低龄化留学利弊。在随后的采访中,万校长向外滩君阐述了他对未来教育发展趋势的思考。他大胆预测,未来学校教育核心学科就只有两门:体育和阅读。不论你的孩子决定走哪种教育体系路线,只要你也觉得未来不可预测,那就来看看万校
- 下一篇
莫言:优秀的父母在这几个方面大都做得很好
莫言曾发表过这样一段博文:“我崇拜反叛父母的孩子,因为我认为敢于最早举起‘反叛大旗’的孩子,必定是治世英雄的雏鸟,父母仅仅会爱并不及格,因为母鸡也会爱,何况最真挚的爱的另一面往往是最苛虐的酷政。父母必须接受训练,具有相当的质量才行。” 那么,在莫言眼里,什么样的父母是好的父母?什么样的父母才
微信收款码
支付宝收款码